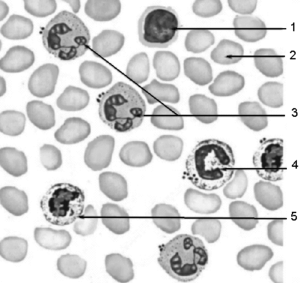

Методичка (1) (1135304), страница 4
Текст из файла (страница 4)
5 – палочкоядерный нейтрофил;
6 – тромбоциты
7 – сегментоядерный нейтрофил; 8 - базофил,
Эритроциты – безъядерные клетки, неспособные к делению. Количество эритроцитов в 1 л крови колеблется у взрослых мужчин: от 3,9 до 5,5 х 1012, у женщин: от 3,7 до 4,9х1012 Большинство эритроцитов имеет форму двояковогнутого диска (дискоциты). Форма диска обеспечивает наибольшую поверхность контакта с плазмой. Общая площадь поверхности всех эритроцитов взрослого человека составляет 3000-3800 м2, что в 1500-1900 раз превышает поверхность тела. Дисковидная форма также обеспечивает и обратимую деформацию (сгибание) эритроцита при прохождении через узкие капилляры.
З
начительная вариабельность форм эритроцитов называется пойкилоцитозом, что характерно для тяжелых формах анемий. Диаметр большинства эритроцитов составляет 7,2 мкм. Колебания размеров эритроцитов от 7,16 до 7,98 мкм считаются нормой – это нормоциты.
В
Рис. 16. Эритроцит
стречаются микроциты, размеры которых 6 мкм и меньше и макроциты размерами свыше 8,5 мкм. Повышенная вариабельность размеров эритроцитов называется анизоцитозом и развивается при отравлениях органическими веществами (например, тринитротолуолом). Плазмолемма эритроцитов имеет толщину около 20 нм и обеспечивает активный перенос О2, СО2, ионов натрия, калия и других веществ. Основной объем эритроцита - 96% сухого остатка - приходится на долю гемоглобина. Гемоглобин обеспечивает дыхательную функцию крови за счет переноса О2 от легких к тканям и СО2 от клеток к легким. По химической структуре гемоглобин является сложным белком, состоящим из четырех белковых молекул глобина и четырех молекул небелковой группы - гема. Гем имеет в своем составе атом железа, способный присоединять и отдавать молекулу кислорода. При этом валентность железа не изменяется, т.е. Fе остается двухвалентным.У мужчин в норме содержится гемоглобина 130-160 г/л, у женщин – (120-140 г/л. Общее количество гемоглобина в пяти литрах крови у человека составляет 700-800 г. Один грамм гемоглобина связывает 1,34 мл кислорода. Разница в содержании эритроцитов и гемоглобина у мужчин и женщин объясняется стимулирующим действием на кроветворение мужских половых гормонов и тормозящим влиянием женских половых гормонов. Гемоглобин синтезируется эритробластами костного мозга. При разрушении эритроцитов гемоглобин после отщепления гема превращается в желчный пигмент – билирубин.
В норме гемоглобин содержится в крови в виде трех физиологических соединений:
-
оксигемоглобин (НЬО2) – гемоглобин, присоединивший О2; находится в артериальной крови, придает ей ярко-алый цвет;
-
восстановленный, или редуцированный, гемоглобин (Hb), отдавший О2, находится в венозной крови, которая имеет более темный цвет, чем артериальная;
-
карбгемоглобин (НЬСО2) – соединение гемоглобина с углекислым газом; содержится в венозной крови.
Средняя продолжительность жизни эритроцитов – 120 дней. Их образование идет в красном костном мозге. Увеличение количества эритроцитов в единице объема крови называется эритроцитозом (полиглобулией, полицитемией), уменьшение - эритропенией.
Таким образом, эритроцит выполняет следующие функции:
-
дыхательную – за счет гемоглобина, присоединяющего к себе 02 и СО2;
-
питательную – адсорбирование на своей поверхности аминокислот и доставка их к клеткам организма;
-
защитную – связывание токсинов находящимися на их поверхности антитоксинами и участие в свертывании крови;
-
ферментативную – перенос различных ферментов: угольной ангидразы (карбоангидразы), истинной холинэстеразы и др.;
-
буферную – поддержание с помощью гемоглобина рН крови в пределах 7,36-7,42;
Лейкоциты. У взрослого человека в 1 литре крови насчитывается 3,8-9х109 лейкоцитов. Увеличение числа лейкоцитов в крови называется лейкоцитозом, а снижение – лейкопенией. Все лейкоциты являются ядерными клетками, способными к активному перемещению. По наличию специфической зернистости в цитоплазме лейкоциты подразделяются на зернистые – гранулоциты и незернистые – агранулоциты. Гранулоциты характеризуются наличием сегментированного ядра, псевдоподий и зернистости в цитоплазме. Гранулоциты по окрашиванию зерен подразделяют на эозинофильные (ацидофильные), базофильные и нейтрофильные* (* – отмечены данные по особенностям методов окраски препаратов, которые приведены в конце пособия). Все зернистые лейкоциты, особенно нейтрофилы, способны к фагоцитозу. Незернистые лейкоциты отличаются несегментированным ядром, отсутствием видимой при световой микроскопии зернистости в цитоплазме. Незернистые лейкоциты менее подвижны, способны к делению. К агранулоцитам относят лимфоциты и моноциты.
Нейтрофилы составляют 65-75% от общего числа лейкоцитов. Различают сегментоядерные, палочкоядерные нейтрофилы и метамиелоциты (юные нейтрофилы). Подавляющую часть лейкоцитов составляют сегментоядерные нейтрофилы – 60-65%. Их диаметр в мазке крови равен 9-12 мкм. Ядра имеют 2-5 сегментов, связанных перемычкой. От одного из сегментов ядра нейтрофила может отходить небольшой вырост, имеющий форму барабанной палочки – это тельце полового хроматина (неактивная Х хромосома). В цитоплазме имеется зернистость двух типов: крупные гранулы,
видимые в световой микроскоп – это лизосомы с гидролитическими ферментами; и мелкие гранулы, видимые только в электронный микроскоп, заполненные бактерицидными веществами.
Палочкоядерные нейтрофилы составляют 3-5%. Ядра этих клеток имеют вид изогнутой палочки или буквы S. Метамиелоциты содержат бобовидное ядро. В крови встречаются редко (0-0,5%).
В лейкоцитарной формуле слева записывают число метамиелоцитов, правее – палочкоядерных нейтрофилов и еще правее – сегментоядерных нейтрофилов. Поэтому увеличение числа молодых форм нейтрофильных гранулоцитов называют «сдвигом формулы влево» Он свидетельствует об усилении кроветворения, что наблюдается при наличии в организме воспалительного процесса, когда из красного костного мозга выходят молодые формы нейтрофильных гранулоцитов. Основная функция нейтрофилов – уничтожение патогенных микроорганизмов путем фагоцитоза. Они разрушают и переваривают также поврежденные клетки и ткани.
Э
Рис. 17. Мазок крови человека.
1 – лимфоцит, 2 – эритроцит,
3 – сегментоядерные нейтрофилы,
4 – палочкоядерный нейтрофил,
5 - метамиелоцит .
Рис. 18. Гранулоциты
(вверху - схема, внизу -
электронная микрофотография )
А - нейтрофильные,
Б - эозинофильные,
В - базофильные.
озинофильные гранулоциты – эозинофилы составляют 1-5% от общего числа лейкоцитов (120-350 эозинофилов в 1 мм3). Диаметр эозинофилов – 12-14 мкм. Ядра, как правило, имеют два сегмента, иногда больше. В цитоплазме содержатся крупные гранулы округлой формы (овальной или полигональной). Оксифильность гранул обусловлена наличием в них основного белка, богатого аминокислотой аргинином. В гранулах эозинофилов имеются электроноплотные структуры, характер которых имеет видовую специфичность (у человека в одной грануле может быть один или несколько кристаллов различной формы, у кошки эозинофильная гранула содержит один кристалл цилиндрической формы). В крови эозинофилы находятся 3-8 часов, в соединительной ткани – несколько дней.Основными функциями эозинофилов являются:
1) уничтожение патогенных микробов путем фагоцитоза, а простейших и многоклеточных паразитов – неклеточным воздействием;
2) эозинофилы являются иммунорегуляторами – они ограничивают область аллергической реакции и синтезируют регуляторы воспаления. Таким образом, увеличение количества эозинофилов в крови – эозинофилия, наблюдается при аллергических состояниях и глистных инвазиях.
Базофильные гранулоциты - базофилы составляют в крови человека 0-1% от общего числа лейкоцитов. Диаметр базофила – 11-12 мкм. Ядра слабодольчатые, окрашиваются слабее, чем ядра эозинофилов и нейтрофилов.
Цитоплазма заполнена большим количеством крупных гранул, имеющих метахроматическую окраску (метахромазией называется способность структур изменять цвет красителя* (* – отмечены данные по особенностям методов окраски препаратов, которые приведены в конце пособия)). Метахромазия гранул связана с наличием в них гепарина. Базофилы участвуют в обеспечении гомеостаза, постоянно синтезируют и выделяют биологически активные вещества (гепарин, гистамин и др.). Базофилы участвуют в защитных реакциях организма, стимулируют функции нейтрофилов и макрофагов, выделяют медиаторы воспаления.
Лимфоциты – одни из основных видов лейкоцитов. Лимфоциты находятся не только в крови, особенно много их в лимфе. В крови взрослых людей лимфоциты составляют 20-35% от общего числа лейкоцитов, у новорожденных до 60%. В зависимости от размеров лимфоцитов, различают малые (4,5-6 мкм), средние (7-10 мкм) и большие (10 мкм и более). Лимфоциты имеют круглое (иногда бобовидное) ядро. Цитоплазма окружает ядро узким ободком, имеет мелкие гранулы – лизосомы.
Ф
ункционально и по происхождению различают Т-лимфоциты и В-лимфоциты. Образование Т- и В-лимфоцитов идет в два этапа. Первый протекает без контакта с антигенами и завершается появлением специфического рецептора к чужеродному антигену. У Т-лимфоцитов этот этап происходит в тимусе, у В-лимфоцитов – в красном костном мозге.
В
Рис. 19. Т-лимфоциты-киллеры, в начале атаки на раковую клетку (1) и в конце (2).
торой этап у Т и В клеток происходит в периферических лимфоидных образованиях (селезенке, лимфатических узлах, и лимфатических узелках в различных органах) и заканчивается формированием эффекторных (рабочих) клеток иммунной системы. Это Т-хелперы, стимулирующие выработку антител,Т-киллеры, уничтожающие чужеродные и измененные собственные клетки и Т-супрессоры, тормозящие синтез антител.
В
Рис. 20. Лимфоциты.
На электронной микрофотографии показаны разные стадии созревания В-лимфоцита.
-лимфоциты образуются в лимфоидной ткани желудочно-кишечного тракта. Под контролем Т-лимфоцитов они синтезируют антитела, обезвреживающие чужеродные агенты. В-лимфоциты сами синтезируют антитела или трансформируются в плазматические клетки, синтезирующие большое разнообразие антител.
Рис. 21. Схема иммунного ответа.
1 - антигены микробов,
2 - фагоцитоз микробов и активизация фагоцита,
3 - взаимодействие фагоцита с Т-лимфоцитом,
4 - размножение и созревание Т-лимфоцитов,